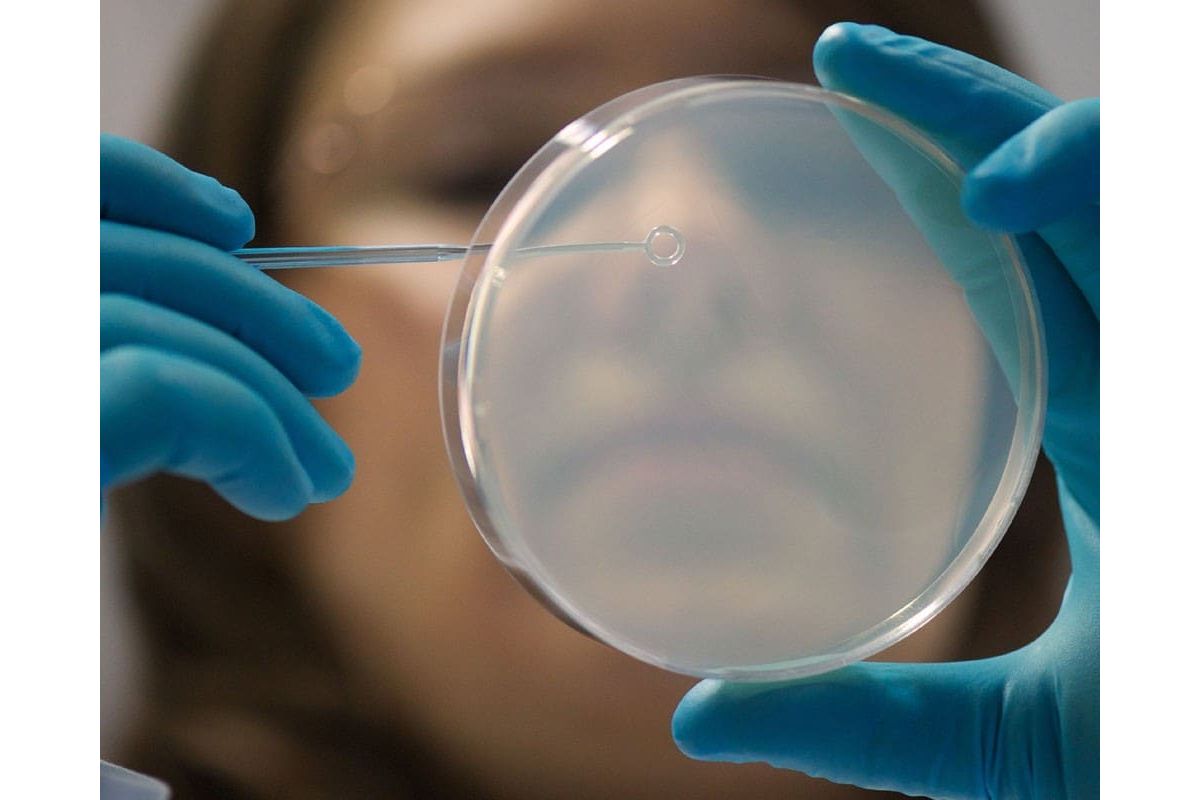

Мікроби основа біокомп’ютера
Вчені з різних куточків світу об’єдналися у дослідницьку групу, аби створити біокомп’ютер, який покращує роботу кишечника та бореться з кишковими інфекціями. Так, біокомп’ютер, створений за допомогою трьох видів мікробів, має здатність керувати поведінкою інших мікроорганізмів та впливати на них.
В основі винаходу – заміна двох штаммів кишечної палички на два інших протилежних за змістом набори генів, що змусило мікроби синтезувати молекули, котрі включають чи виключають певний набір генів в третьому різновиді мікробів.
Таким чином, новий винахід можна порівняти з електронним маятником, який синхронізуватиме роботу окремих компонентів та вироблятиме ліки, підвищуючи активність мікрофлори кишечника.